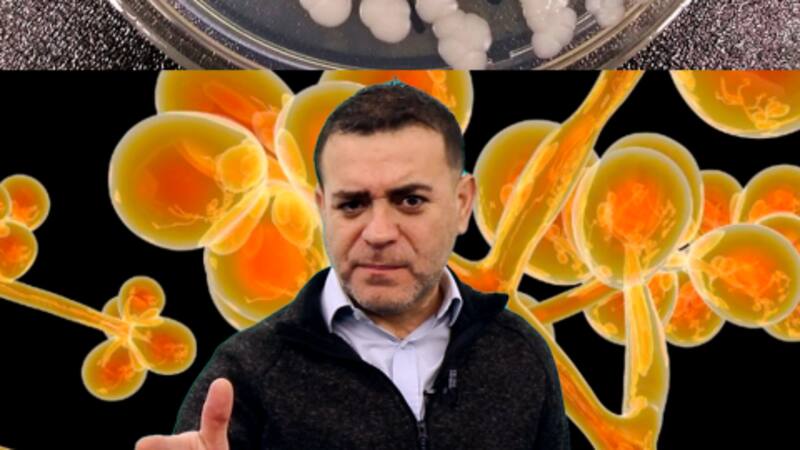

¿Qué hongo es el que se está propagando por EE.UU. y es considerado una amenaza para la salud mundial?
Las autoridades norteamericanas han informado de la peligrosa propagación de un hongo conocido como Candida auris, y que se ha estado propagando a un ritmo alarmante en los hospitales de EEUU entre 2020 y 2021. Acá te lo contamos.
COMENTARIOS
Para comentar este artículo debes ser suscriptor.